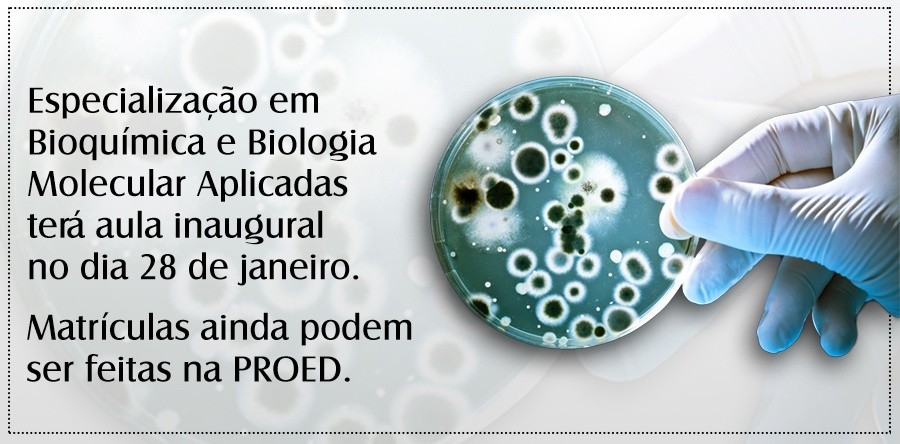
Especialização em Bioquímica e Biologia Molecular Aplicadas terá aula inaugural no dia 28 de janeiro. Matrículas ainda podem ser feitas na PROED

Especialização em Bioquímica e Biologia Molecular Aplicadas terá aula inaugural no dia 28 de janeiro. Matrículas ainda podem ser feitas na PROED
20 de janeiro de 2017 - 11:18 AM
A Pró-Reitoria de Educação Continuada da Universidade Estadual Vale do Acaraú (PROED/ UVA) promoverá palestra sobre “Pesquisa Científica em Sobral nos campos da Saúde, Meio Ambiente e Agropecuária” proferida pelo Prof. Daniel de Brito – Mestre em Biotecnologia e Doutor em Bioquímica pela UFC e Pós-Doutor em Biotecnologia Marinha pelo Instituto Politécnico de Leiria, Portugal. O evento é aberto e terá início às 8h30min, na sala seis do prédio do Centro de Ciências da Saúde (CCS), no campus do Derby, no dia 28 de janeiro de 2017.
A palestra será a aula inaugural do Curso de Pós-Graduação lato sensu em Bioquímica e Biologia Molecular Aplicadas, com ênfase em Saúde, Meio Ambiente e Agropecuária e o Prof. Daniel de Brito abordará também a importância da educação continuada nessa área.
Com 360 horas/ aula, o curso é voltado a graduados e profissionais das áreas de Biologia, Enfermagem, Medicina, Veterinária, Química e Zootecnia. As matrículas ainda estão abertas e podem ser feitas na PROED, no campus Betânia. As aulas serão ministradas em três sábados no mês, no horário de 8h às 17h. Saiba mais: (88)3611-6669 ou pelo e-mail: proed@uvanet.br
Veja a Matriz Curricular do Curso:
Módulo Básico Teórico (120 horas)
>Bioquímica
>Biologia Celular e Molecular
>Metodologia do Trabalho Científico
>Microbiologia e Parasitologia
Módulo Básico Prático (100 horas)
>Biossegurança
>Introdução à Prática de Biologia Molecular
>Introdução à Prática de Bioquímica e Imunologia
>Introdução à Prática de Microbiologia
>Seminários I
Módulo Avançado (140 horas)
>Genômica e Proteômica
>Bioinformática
>Citometria de Fluxo
>Cultura de Células e Tecidos
>Transformação genética de bactérias e expressão de
proteínas heterólogas
>Bioquímica e Biologia Molecular aplicadas ao Diagnóstico Clínico
>Seminários II
Você pode compartilhar esta notícia em suas redes sociais, acessando os ícones abaixo.
20/01/2017
Assessoria de Comunicação e Marketing Institucional da UVA
Universidade Estadual Vale do Acaraú – UVA
(comunicacao@uvanet.br / 88 3677-4271)